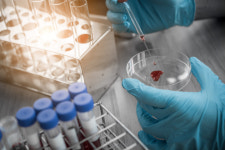
대전시, 바이오메디컬 규제자유특구 시동

킹스톤바이오메디컬 총79명이 열람하였으며, 0개의 리뷰가 있습니다.
- 번호
- 56,215
- 개방서비스명
- 의료기기판매(임대)업
- 개방서비스아이디
- 01_02_03_P
- 개방자치단체코드
- 3,230,000
- 관리번호
- PHMG120203230034047000138
- 인허가일자
- 2020-07-06
- 영업상태구분코드
- 1
- 영업상태명
- 영업/정상
- 상세영업상태코드
- 13
- 상세영업상태명
- 영업중
- 소재지전체주소
- 서울특별시 송파구 석촌동 ** 대호빌딩
- 도로명전체주소
- 서울특별시 송파구 백제고분로**길 **, 대호빌딩 *층 (석촌동)
- 도로명우편번호
- 5,611
- 사업장명
- 킹스톤바이오메디컬
- 최종수정시점
- 2020-07-07 15:52:22
- 데이터갱신구분
- I
- 데이터갱신일자
- 2020-07-09 00:23:16
- 좌표정보x(epsg5174)
- 127
- 좌표정보y(epsg5174)
- 38
주변 목록 (8)
(주)코리아세븐 뉴스타점
서울특별시 송파구 석촌동 *-* 광명빌딩
'킹스톤바이오메디컬'에서 0km
서울특별시 송파구 석촌동 *-* 광명빌딩
바로가기
GS THE FRESH 송파석촌호수점
서울특별시 송파구 석촌동 *-*
'킹스톤바이오메디컬'에서 0.1km
서울특별시 송파구 석촌동 *-*
바로가기
(주)프레쉬스토리
서울특별시 송파구 석촌동 *번지 *호 블레스빌
'킹스톤바이오메디컬'에서 0.1km
서울특별시 송파구 석촌동 *번지 *호 블레스빌
바로가기
(주)오래온코리아
서울특별시 송파구 석촌동 **-** 석촌호수 나인파크 B
'킹스톤바이오메디컬'에서 0.1km
서울특별시 송파구 석촌동 **-** 석촌호수 나인파크 B
바로가기
지에스(GS)25 석촌스카이점
서울특별시 송파구 석촌동 *-* 리엘타워
'킹스톤바이오메디컬'에서 0.1km
서울특별시 송파구 석촌동 *-* 리엘타워
바로가기
휴
서울특별시 송파구 석촌동 *-* 신동아 로쟌뷰 ****호
'킹스톤바이오메디컬'에서 0.1km
서울특별시 송파구 석촌동 *-* 신동아 로쟌뷰 ****호
바로가기
세븐일레븐 석촌카페점
서울특별시 송파구 석촌동 *번지 *호 신동아로쟌뷰
'킹스톤바이오메디컬'에서 0.1km
서울특별시 송파구 석촌동 *번지 *호 신동아로쟌뷰
바로가기
㈜한국비엔디
서울특별시 송파구 석촌동 *번지 **호 양촌빌딩
'킹스톤바이오메디컬'에서 0.2km
서울특별시 송파구 석촌동 *번지 **호 양촌빌딩
바로가기
주변 의료기기 수리업 (12)
(주)메디스타
서울특별시 송파구 석촌동 60번지 3호 3층
'킹스톤바이오메디컬'에서 0.29km
바로가기
엘지전자(주) 송파서비스센터
서울특별시 송파구 송파동 7번지
'킹스톤바이오메디컬'에서 0.61km
바로가기
(주)스타키보청기 잠실 디지털센터
서울특별시 송파구 송파1동 84번지 7호 안흥빌딩 501호
'킹스톤바이오메디컬'에서 0.81km
바로가기
(주)메디플랜
서울특별시 송파구 송파1동 22번지 향나무빌딩 4층
'킹스톤바이오메디컬'에서 0.84km
바로가기
한국다케다제약(주)
서울특별시 송파구 신천동 29 롯데월드타워앤드롯데월드몰
'킹스톤바이오메디컬'에서 0.94km
바로가기
(A+)늘찬복지용구
서울특별시 송파구 송파동 93-5 보승빌딩
'킹스톤바이오메디컬'에서 1.1km
바로가기
에르베메디칼코리아 유한회사
서울특별시 송파구 신천동 7-20 한국루터회관
'킹스톤바이오메디컬'에서 1.15km
바로가기
에스지메디칼(주)
서울특별시 송파구 방이동 65번지 7호 한길빌딩
'킹스톤바이오메디컬'에서 1.21km
바로가기
(주)씨젠
서울특별시 송파구 방이동 65번지 태원빌딩
'킹스톤바이오메디컬'에서 1.22km
바로가기
금강보청기 송파센터
서울특별시 송파구 잠실동 184-7
'킹스톤바이오메디컬'에서 1.39km
바로가기
공영무역(주)
서울특별시 송파구 방이2동 149번지 4호 순창빌딩 2,3층
'킹스톤바이오메디컬'에서 1.57km
바로가기
(주)엠코리아토탈서비스
서울특별시 강남구 일원동 641-4
'킹스톤바이오메디컬'에서 1.71km
바로가기
주변 부속 의료기관 (12)
삼성에스디에스(주)부속의원
'킹스톤바이오메디컬'에서 1.21km
바로가기
씨젠부속의원
서울특별시 송파구 방이동 22-3 씨젠송파빌딩
'킹스톤바이오메디컬'에서 1.3km
바로가기
메디톡스부속의원
서울특별시 강남구 대치동 997번지 4호 지하1층
'킹스톤바이오메디컬'에서 2.9km
바로가기
서울동부구치소부속의원
서울특별시 송파구 문정동 648번지
'킹스톤바이오메디컬'에서 3.04km
바로가기
서울동부지방법원부속의원
서울특별시 송파구 문정동 650번지 서울동부지방법원
'킹스톤바이오메디컬'에서 3.06km
바로가기
멀츠아시아퍼시픽피티이엘티디(영업소)부속의원
서울특별시 강남구 삼성동 158번지 16호 엔씨타워 I, 4층일부
'킹스톤바이오메디컬'에서 3.6km
바로가기
메디스트림부속한의원
서울특별시 강남구 삼성동 143-40 위워크타워 3층 일부
'킹스톤바이오메디컬'에서 3.99km
바로가기
바디프랜드부속의원
서울특별시 강남구 도곡동 448-2 바디프랜드 도곡타워
'킹스톤바이오메디컬'에서 5.54km
바로가기
서초삼성부속치과의원
'킹스톤바이오메디컬'에서 6.43km
바로가기
서초삼성부속의원
서울특별시 서초구 서초동 1320번지 10호 삼성전자빌딩
'킹스톤바이오메디컬'에서 6.43km
바로가기
코코네엠부속의원
'킹스톤바이오메디컬'에서 6.68km
바로가기
(주)제이시스메디칼부속의원
서울특별시 강남구 논현동 49-4 신영와코루빌딩
'킹스톤바이오메디컬'에서 6.9km
바로가기
주변 의료 유사업 (12)
청평안마원
서울특별시 송파구 석촌동 210번지 공익빌딩 405호
'킹스톤바이오메디컬'에서 0.4km
바로가기
팜스케어안마원
서울특별시 송파구 석촌동 295번지 9호 3층
'킹스톤바이오메디컬'에서 0.97km
바로가기
늘함안마원
'킹스톤바이오메디컬'에서 1.35km
바로가기
건강한지압안마원
서울특별시 송파구 방이동 110번지 6호
'킹스톤바이오메디컬'에서 1.47km
바로가기
쉼표안마원
일원동 663번지 5호 지하 1층
'킹스톤바이오메디컬'에서 1.97km
바로가기
클린안마센터서울5호점
서울특별시 강남구 개포동 12 대치아파트
'킹스톤바이오메디컬'에서 2.44km
바로가기
강남건강안마센터
서울특별시 강남구 개포동 12번지 4호 석탑프라자
'킹스톤바이오메디컬'에서 2.5km
바로가기
어머니약손안마원
서울특별시 강남구 대치동 316번지 은마아파트 상가 202호
'킹스톤바이오메디컬'에서 3.1km
바로가기
명지압안마원
서울특별시 광진구 자양동 679-28 태솔타운 1동 201호
'킹스톤바이오메디컬'에서 3.18km
바로가기
백세지압안마원
서울특별시 강남구 대치동 957-11
'킹스톤바이오메디컬'에서 3.59km
바로가기
힐링스토리
서울특별시 광진구 자양동 626-2 1층
'킹스톤바이오메디컬'에서 3.63km
바로가기
디올안마시술소
서울특별시 광진구 자양동 216번지 4호
'킹스톤바이오메디컬'에서 3.67km
바로가기
주변 의료법인 (12)
의료법인 문원의료재단
서울특별시 송파구 가락본동 2번지 3-4
'킹스톤바이오메디컬'에서 2.28km
바로가기
의료법인일맥의료재단
서울특별시 송파구 문정동 17-5 인애가한방병원
'킹스톤바이오메디컬'에서 3.37km
바로가기
의료법인 가산의료재단
서울특별시 강남구 삼성1동 161번지
'킹스톤바이오메디컬'에서 3.39km
바로가기
의료법인미래의료재단
'킹스톤바이오메디컬'에서 3.54km
바로가기
의료법인 혜민재단
서울특별시 광진구 자양동 627번지 3호
'킹스톤바이오메디컬'에서 3.57km
바로가기
의료법인 정애의료재단
서울특별시 송파구 풍납동 496번지 5호
'킹스톤바이오메디컬'에서 3.71km
바로가기
의료법인중앙의료재단
서울특별시 강남구 자곡동 633 S-플라자 3층 303호
'킹스톤바이오메디컬'에서 3.75km
바로가기
의료법인유투의료재단
서울특별시 송파구 마천동 42번지 7호
'킹스톤바이오메디컬'에서 4.33km
바로가기
의료법인 성심의료재단
'킹스톤바이오메디컬'에서 4.68km
바로가기
의료법인성광의료재단
서울특별시 강남구 역삼1동 650번지 9호
'킹스톤바이오메디컬'에서 5.69km
바로가기
의료법인 삼광의료재단
서울특별시 서초구 양재동 9번지 60호 삼광빌딩
'킹스톤바이오메디컬'에서 5.76km
바로가기
의료법인세원의료재단
서울특별시 강남구 역삼동 606번지 13호
'킹스톤바이오메디컬'에서 5.78km
바로가기
주변 병원 (12)
엠에스병원
서울특별시 송파구 삼전동 180-8 태영빌딩
'킹스톤바이오메디컬'에서 0.43km
바로가기
강철병원
서울특별시 송파구 삼전동 72-2 SH타워
'킹스톤바이오메디컬'에서 0.54km
바로가기
한솔병원
서울특별시 송파구 석촌동 174번지 13호 한솔병원
'킹스톤바이오메디컬'에서 0.62km
바로가기
서울오브치과병원
서울특별시 송파구 삼전동 28-6
'킹스톤바이오메디컬'에서 0.95km
바로가기
빠른병원
서울특별시 송파구 송파동 20번지 7호 유니온테크송파빌딩
'킹스톤바이오메디컬'에서 0.97km
바로가기
강남힘찬병원
서울특별시 송파구 송파1동 20번지 8호 지하2층~지상7층
'킹스톤바이오메디컬'에서 0.99km
바로가기
연세우리병원
'킹스톤바이오메디컬'에서 1.03km
바로가기
강남푸른숲한방병원
'킹스톤바이오메디컬'에서 1.1km
바로가기
미래본병원
'킹스톤바이오메디컬'에서 1.1km
바로가기
포레메디한방병원
서울특별시 송파구 방이동 109번지 3호
'킹스톤바이오메디컬'에서 1.17km
바로가기
강남수병원
서울특별시 송파구 삼전동 38-5
'킹스톤바이오메디컬'에서 1.22km
바로가기
서재곤링커병원
서울특별시 송파구 송파동 135번지 3호 4,14,15
'킹스톤바이오메디컬'에서 1.23km
바로가기
블로그 리뷰
-
현재 킹스턴 대학교 약학과 4학년 재학 중이며, English School UK의 Student Success Coordinator로 활동 중인 Taylor Joo 선생님이 현장에서 체감하는 변화와 약대 진학 과정 및 진로 등 꼭 필요한 정보에 대해 생생한 이야기를 들려드리고 있습니다. English School UK에서는 A-Level, IB, 파운데이션 등 다양한 루트...
English School UK - 국제학교 전문 온라인 아카데미(2025-07-28 10:48:00)

-
랜딩 후기 (토론토 피어슨공항) feat. 눈보라가 나를 맞이해주는구나 드디어 캐나다 영주권 랜딩이 다가왔다...! 나의 COPR이 23년 3월 24일까지여서 정말 토론토를 여름에 ... m.blog.naver.com 드디어 랜딩 🍯 토론토, 여름 특히 코로나시기에 다사다난 산전수전공중전을 겪고 캐나다에서 급 귀국해서 한국에서...
윤데이즈의 행방(2022-06-24 21:45:00)

일별 방문 통계
월별 방문 통계
카카오맵 바로가기
카카오맵 위치 기준 길안내
리뷰 (0)
등록된 리뷰가 없습니다.
관련 지도 선택 및 번역
첨부파일










![[국민의 기업] 메디컬융합소재실용화센터 통해 지역 바이오산업 경쟁력 업그레이드](https://search.pstatic.net/common/?type=b150&src=http%3A%2F%2Fimgnews.naver.net%2Fimage%2F025%2F2022%2F10%2F26%2F0003233493_001_20221026054826039.jpg)